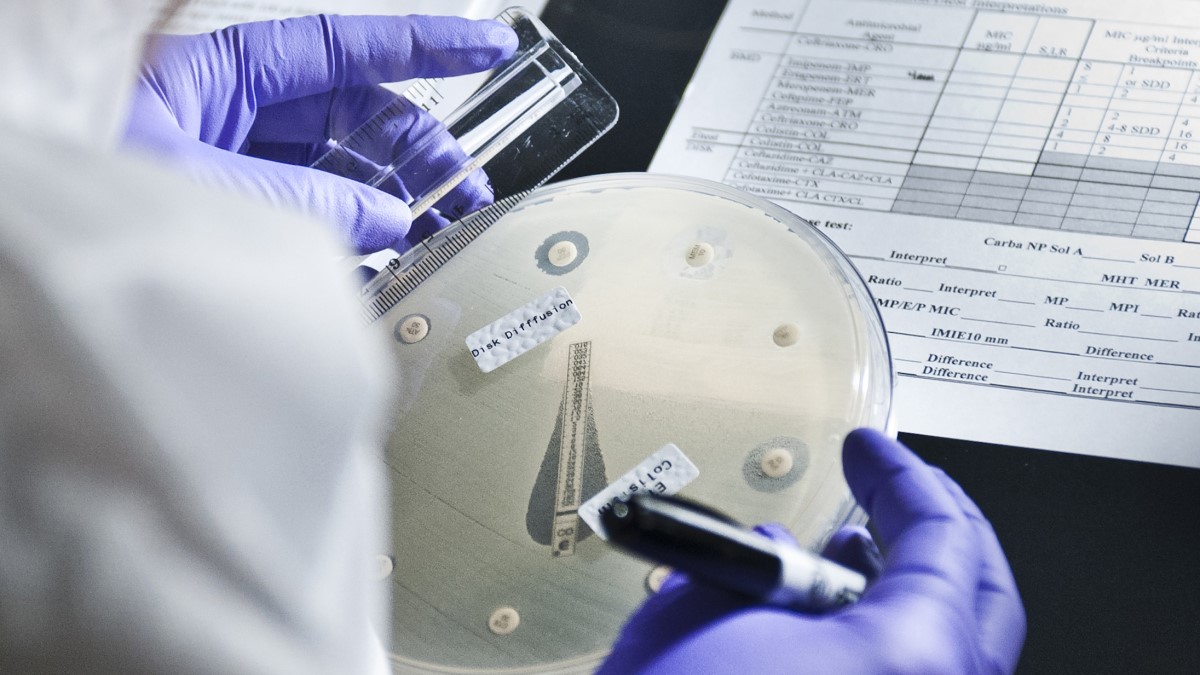
LAARC Thumbnail Laboratorian working in the lab.

At a glance
- The Laboratory Assessment of Antibiotic Resistance Testing Capacity (LAARC) is a laboratory assessment tool for use in clinical bacteriology laboratories in low- and middle-income countries.
- It was developed in 2017 and piloted in numerous resource-limited settings.
- If you use the LAARC, please consider filling out the Optional LAARC User Registration at the bottom of this page to receive notifications when CDC edits or updates the tool.
- The Laboratory Assessment of Antibiotic Resistance Testing Capacity (LAARC) is a laboratory assessment tool for use in clinical bacteriology laboratories in low- and middle-income countries.
- It was developed in 2017 and piloted in numerous resource-limited settings.
- If you use the LAARC, please consider filling out the Optional LAARC User Registration at the bottom of this page to receive notifications when CDC edits or updates the tool.
Purpose
The Laboratory Assessment of Antibiotic Resistance Testing Capacity (LAARC) helps laboratories identify and correct laboratory practices that contribute to inaccurate antimicrobial resistance (AR) data.
Use LAARC for:
- Self-assessment of technical deficiencies.
- Facilitating a standardized external assessment of AR laboratory networks.
LAARC materials
- LAARC User's Guide and Questionnaire
LAARC tool user registration
The Excel-based scoring tool:
- Is available in English, French, Spanish and Portuguese.
- Generates numerical indicators of quality and capacity in fifteen domains of laboratory practice.
- Provides detailed real-time heatmaps for immediate visualization of problem areas.
- Flags key responses that require urgent correction.
- Aids development of workplans for improvement.
- Can be used to monitor the status of laboratory improvements over time.
- Allows data to be exported and collated for comparative analysis of multiple laboratories.
Page Accessibility
Optional LAARC User Registration
Please consider completing the following fields to register your use of the LAARC. Registration is optional. If you register, CDC will notify you of updates and changes to the LAARC tool. In addition, CDC may request feedback to improve the tool or ask you to participate in research to better understand antimicrobial resistance laboratory findings from around the world. Sharing information is optional.